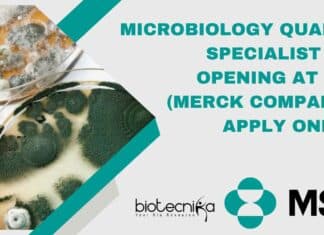
Microbiology Quality Specialist Job Opening at MSD (Merck Company) – Apply Online Microbiology Quality Specialist Job

GSK Scientific Writing Job Openings For Life Sciences – Apply Online
GSK Scientific Writing Job Openings For Life Sciences - Apply Online
Senior Scientific Writer Bengaluru, India
Medical and Clinical
394538
Job description
Site Name: Bengaluru Luxor North Tower
...
Hershey’s Food Tech & Microbiology Quality Assurance Job Opening – Apply...
Hershey's Food Tech & Microbiology Quality Assurance Job Opening - Apply Online
Senior Officer/ Executive - QA
Posted Date: Apr 23, 2024
Requisition Number: 121760
Location: Mandideep, Bhopal
Position:...
University of Delhi Vice Chancellor Internship Scheme: Summer Internship 2024 With...
Delhi University Summer Internship 2024 With Rs. 10,000 pm Stipend - Apply Now!
Introduction
An internship enhances students' skills by providing experiential learning that combines cognitive...
International Conference on “Intracellular Quality and Metabolic Control from E. Coli...
International Conference on “Intracellular Quality and Metabolic Control from E. Coli to HomoSapiens” at MIRM-MAHE Bangalore
27-29 August 2024
MIRM – MAHE, Bangalore
Manipal Institute of Regenerative...
MSc Biological Sciences Junior Research Fellow Role at CSIR-IICB – Apply...
CSIR-IICB JRF Vacancy Biological Sciences - Apply Now
Advertisement No.: R&C/574/2024
Date of Advertisement: 22/04/2024
Vacancy Code: 5742414
Position: Junior Research Fellow
No. of Vacancies: 1
Walk-in Interview on: 21/05/2024
Reporting...
SGPGIMS MSc Genetics, Life Sciences Project Job Opening – Applications Invited
SGPGIMS MSc Genetics, Life Sciences Project Job Opening - Applications Invited
Department of Surgical Gastroenterology
Sanjay Gandhi Postgraduate Institute of Medical Sciences, Lucknow, India
Advertisement
Applications are invited...
UGC’s Big Announcement: No Score Normalization in NET & CUET-UG From...
No Score Normalization in NET & CUET-UG From This Year!
UGC Chairman M. Jagadesh Kumar announced a change in the way scores are adjusted for...
Biotecnika Times Newsletter 23.04.2024 – Navodaya Vidyalaya Samiti TGT & PGT...
Navodaya Vidyalaya Samiti TGT & PGT Recruitment - Applications Invited Online
Applications are invited online for the Navodaya Vidyalaya Samiti TGT PGT recruitment.
Gujarat Biotechnology University...
Panacea Biotec Executive Validation Role Available – Apply Online
Panacea Biotec Executive Validation Role Available - Apply Online
Executive - Validation & Qualification
Manufacturing Unit: Baddi, Himachal Pradesh, India
Department: Validation / Qualification
Job posted on: Apr...
Microbiology Quality Specialist Job Opening at MSD (Merck Company) – Apply...
Microbiology Quality Specialist Job Opening at MSD (Merck Company) - Apply Online
Specialist Quality
Location: Pune, Maharashtra, India
Job Type: Full-Time
This site is for Residents of Europe,...
Navodaya Vidyalaya Samiti TGT & PGT Recruitment – Applications Invited Online
Navodaya Vidyalaya Samiti TGT & PGT Recruitment - Applications Invited Online
NAVODAYA VIDYALAYA SAMITI, REGIONAL OFFICE, BHOPAL
Notification – 01/2024-25
ONLINE APPLICATIONS INVITED FOR ENGAGEMENT OF TEACHERS ON...
CIAB Biotechnology Fellowships Recruitment – Attend Walk-In-Interview
CIAB Biotechnology Fellowships Recruitment - Attend Walk-In-Interview
CENTER OF INNOVATIVE AND APPLIED BIOPROCESSING
Department of Biotechnology, Ministry of Science & Technology (Govt. of India) Sector-81 (Knowledge...
JRF Position at Panjab University – MSc Life Sciences, Biotech, Biochem...
JRF Position at Panjab University - MSc Life Sciences, Biotech, Biochem & Microbiology Apply
Department of Biotechnology, Panjab University
BMS-1, South Campus, Sector-25, Chandigarh-160014, INDIA
Phone: 0172-2534085...
Gujarat Biotechnology University In Partnership with The University of Edinburg MSc...
GBU MSc Biotechnology Admissions 2024 - Apply Online
GUJARAT BIOTECHNOLOGY UNIVERSITY
In partnership with THE UNIVERSITY of EDINBURGH
India's First Biotechnology University
(Established by Government of Gujarat)
M.Sc....
Dr. Reddy’s Recruitment Drive For MSc, BTech & MTech Biotech, Life...
Dr. Reddy's Recruitment Drive For MSc, BTech & MTech Biotech, Life Sciences - Register Now!
Dr. Reddy's Recruitment Drive
Pune Biologics - Drug Substance
Work Location: Bachupally,...